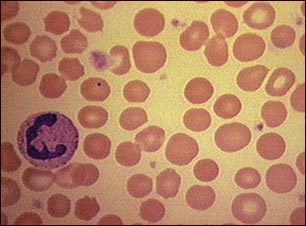
Gl&oacute;bulos rojos con esferocitosis

![]() | ![]() | ![]() |
Glóbulos rojos con esferocitosis
La esferocitosis es un trastorno hereditario de los glóbulos rojos que puede estar relacionado con la anemia leve. Los glóbulos rojos afectados por lo general son pequeños y esféricos y carecen de los centros claros que se observan en los glóbulos rojos normales redondos
Actualizado: 8/10/2008
